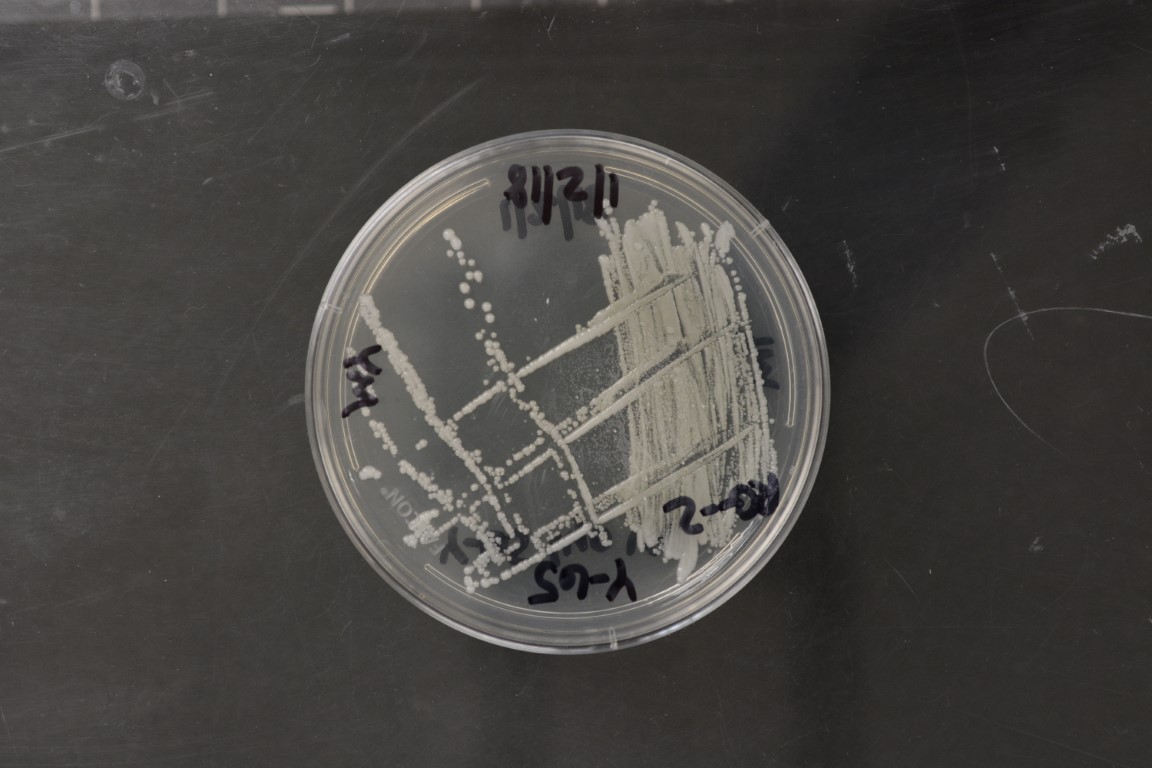

Candida glabrata
NRRL Y-65(Type Strain)
Accession numbers in other collections:AJ 5402=ATCC 2001=ATCC 36583=CBS 138=CCRC 20586=DBVPG 3828=IFO 0622=IGC 2418=JCM 3761=NRRL Y-1417=VKM Y-1481
Source:Clark,University of Illinois,Urbana,Illinois
Isolated from(substrate):DG,human feces(Tanner collection)
Genetic info:Robnett PCR#246,1 diff.D1/D2 and 6 diff.ITS with Y-17815,0 diff.D1/D2 with Y-7300.GenBank:D1/D2(U44808),SSU(AY046237),ITS(AY046165).
Growth media:Yeast Extract-Malt Extract-Peptone-Glucose(YM for yeasts)(number 6)
Optimum growth temperature:25C
Strain images:
NRRL_Y-65_6.JPG

Comments:Nakaseomyces clade